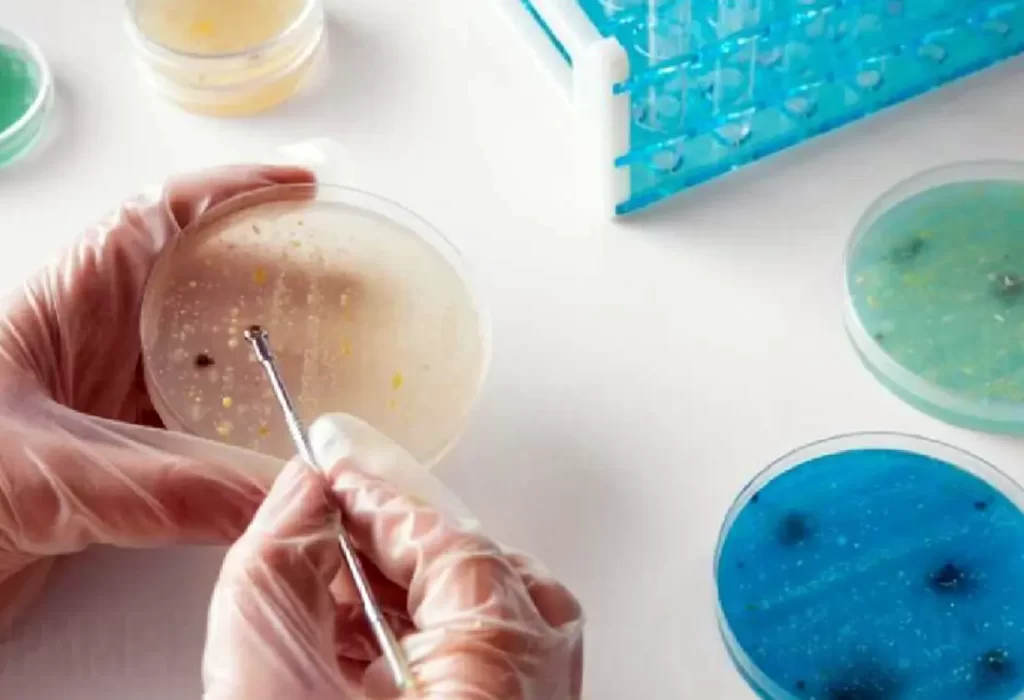

Descubren bacteria con propiedades anticancerígenas en la Amazonía brasileña
En un hallazgo que podría representar un avance significativo en el tratamiento contra el cáncer, un grupo de científicos brasileños ha descubierto una bacteria en el suelo de la selva amazónica que posee propiedades similares a las de la quimioterapia. El estudio, publicado en la revista Scientific Reports, revela que la bacteria ‘Pseudomonas aeruginosa’ es capaz de reducir en un 50% el crecimiento de las células cancerosas e impedir su multiplicación durante 72 horas.
Según el comunicado emitido por el Instituto Vale de Tecnología y la Universidad Federal del Sur y Sudeste de Pará, los investigadores afirman que la bacteria encontrada en el suelo amazónico de Pará es tan eficiente como los tratamientos convencionales contra el cáncer.
Además de su potencial contra los tumores malignos, este sorprendente hallazgo en la selva amazónica podría ser clave para destruir otras bacterias y virus de interés veterinario, como el herpes o el coronavirus murino, que infecta a los ratones.
La investigadora Sidnei Cerqueira señaló que el compuesto hallado podría ayudar a combatir los efectos de la contaminación que afecta a la Amazonía brasileña y pone en peligro su subsistencia, ya que sería capaz de inhibir la toxicidad en suelos contaminados por metales pesados.
Por su parte, el científico José Pires destacó que el suelo amazónico es un terreno fértil en el que se pueden desarrollar bacterias con gran «interés farmacéutico«, fundamentales para la salud humana.
Este descubrimiento en la selva amazónica abre nuevas perspectivas en el tratamiento contra el cáncer de mama y otras enfermedades, aprovechando los recursos naturales de esta región y su biodiversidad única.
DESCARGAR APLICACIÓN DE LA RADIO EN VIVO
 Gracias por estar en Diario Pampero, visítanos para estar informado!
Gracias por estar en Diario Pampero, visítanos para estar informado!
Si necesitas parte de este contenido, no olvides citar la fuente de información. Respetamos a quienes producen contenidos, artículos, fotos, videos. Compartimos información de La Pampa para los pampeanos y te informamos sobre toda la actualidad nacional e internacional destacada.
Si compartes nuestro contenido, nos ayudas a crecer como medio de comunicación!
















